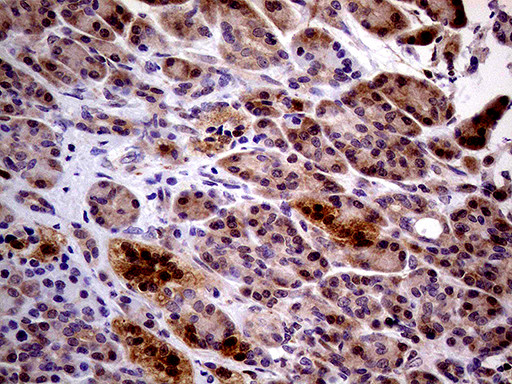
PCMT1 Antibody in Immunohistochemistry (Paraffin) (IHC (P))

Search
OriGene
PCMT1 Monoclonal Antibody (OTI2A9), TrueMAB™
{{$productOrderCtrl.translations['antibody.pdp.commerceCard.promotion.promotions']}}
{{$productOrderCtrl.translations['antibody.pdp.commerceCard.promotion.viewpromo']}}
{{$productOrderCtrl.translations['antibody.pdp.commerceCard.promotion.promocode']}}: {{promo.promoCode}} {{promo.promoTitle}} {{promo.promoDescription}}. {{$productOrderCtrl.translations['antibody.pdp.commerceCard.promotion.learnmore']}}
产品信息
TA809966
种属反应
宿主/亚型
分类
类型
克隆号
抗原
偶联物
形式
浓度
规格
纯化类型
保存液
内含物
保存条件
运输条件
靶标信息
Three classes of protein carboxyl methyltransferases, distinguished by their methyl-acceptor substrate specificity, have been found in prokaryotic and eukaryotic cells. The type II enzyme catalyzes the transfer of a methyl group from S-adenosyl-L-methionine to the free carboxyl groups of D-aspartyl and L-isoaspartyl residues. These methyl-accepting residues result from the spontaneous deamidation, isomerization, and racemization of normal L-aspartyl and L-asparaginyl residues and represent sites of covalent damage to aging proteins PCMT1 (EC 2.1.1.77) is a protein repair enzyme that initiates the conversion of abnormal D-aspartyl and L-isoaspartyl residues to the normal L-aspartyl form.
仅用于科研。不用于诊断过程。未经明确授权不得转售。
篇参考文献 (0)
生物信息学
蛋白别名: epididymis secretory sperm binding protein; L-isoaspartyl protein carboxyl methyltransferase; PIMT; Protein L-isoaspartyl/D-aspartyl methyltransferase; Protein-beta-aspartate methyltransferase; Protein-L-isoaspartate(D-aspartate) O-methyltransferase; unnamed protein product
基因别名: PCMT1; PIMT
UniProt ID: (Human) P22061
Entrez Gene ID: (Human) 5110